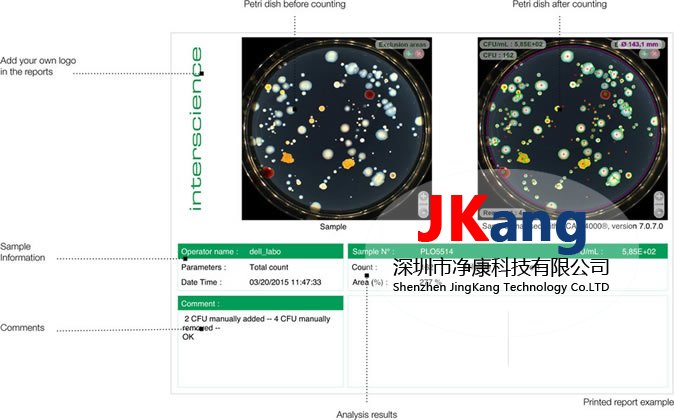

SCAN1200自动高清菌落计数仪,INTERSCIENCE SCAN1200菌落计数器详细介绍:
SCAN1200自动高清菌落计数仪,INTERSCIENCE SCAN1200菌落计数器
SCAN1200自动高清菌落计数仪,INTERSCIENCE SCAN1200菌落计数器是带有自动照明的高分辨率自动彩色菌落计数器。它广泛用于食品微生物学中,可对菌落计数并自动将所有数据保存到Excel™。配有相机和软件,它通过USB连接到PC。
1.高分辨率和高性能
• 最小菌落尺寸:0.05毫米。
• 1秒内检测到1000个菌落CFU。
• 实时图像(x28变焦)。
• 在5分钟内计算30道菜(根据实际情况进行预设)。
•全自动照明:计算机控制的照明和电动背景色。
2.依靠:

3.软件效率
• 所有功能均在1个窗口中。
• 自动优化对比度,亮度和灵敏度。
•琼脂缺陷的自动校正。
•自动分离融合菌落。
•自动消除计数网格。
•在每个计数的菌落上划线。
•多边形排除区域。
•预设媒体:PCA / TSA,MRS,VRBL,TBX,TSC,Baird Parker,GVPC,L.Mono,YM。

4.琼脂井禁区
•快速检测:1次点击最多可检测8种抗生素。
•抑制区和琼脂孔可以手动添加或删除
•内置抗生素数据库(CA-SFM,法国微生物学会)。
•抑制区测量精度:0.3毫米。
•琼脂孔的测量精度:0.3毫米。
•阅读:穆勒·欣顿琼脂,血琼脂,巧克力琼脂。
5.完全可追踪性。
•团队内部结果的协调。
•自动存档和打印数据:图片,注释和结果。
•外部可追溯性(会话保存,Excel™,PDF,JPEG,BMP,Scan®打印的报告)。
•内部可追溯性(条形码,文件存档,LIMS连接)。
•会议的安全(符合CFR 21第11部分:系统安全,操作控制和文档管理)。
6.出色的可复制性和可重复性。
•GLP(良好实验室规范)。
•CFR 21第11部分。
扫描®软件
扫描®自动菌落计数使用由INTERSCIENCE developped独家软件:进化,用户界面友好,功能强大。
SCAN1200自动高清菌落计数仪,INTERSCIENCE SCAN1200菌落计数器软件有许多优点:
•仅需计数一次。
•仅一个设置光标。
•可追溯性:自动保存数据,Excel™导出。
1.可视化窗口。
检测到的菌落突出显示并标有叉号。
2.参数窗口。
只有一个光标可以优化计数。可定制的设置,适用于任何一种琼脂。
3.结果窗口。
可以随时检查所有以前记录的数据。
SCAN1200自动高清菌落计数仪,INTERSCIENCE SCAN1200菌落计数器轻松导出数据。
Scan®软件提供了快速导出结果的简便方法:
• 工作会议保存。
•PDF导出。
•JPEG,BMP导出。
•结果导出到Excel™。
•扫描®打印的报告。
SCAN®打印报告
示例计数前后检查图像,以获取完整的样品信息,注释和结果。
SAG: SCAN1200,INTERSCIENCE SCAN1200,SCAN1200菌落计数器,INTERSCIENCE菌落计数器,自动高清菌落计数仪,SCAN1200高清菌落计数仪


[VIP第4年] 指数:1



